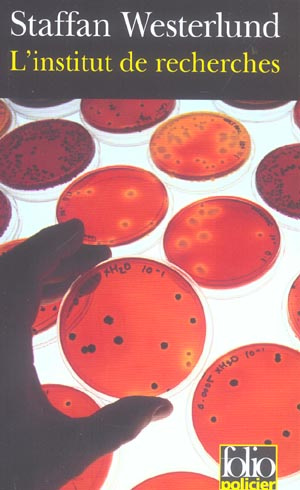
L'Institut de recherches. Une enquête d'Inga-Lisa Ostergren

L'Institut de recherches. Une enquête d'Inga-Lisa Ostergren
Deux incendies criminels, une poursuite en bateau qui se termine par la mort de tous les participants, et nous voilà lancés dans une étrange aventure. L?avocate Inga-Lisa Östergren finira par être troublée par les circonstances de la disparition de sa s?ur et commencera alors à tirer des fils qui la mèneront bien plus loin qu?elle ne s?y attendait, jusqu?en Amérique, sur la trace de savants biologistes dont les activités ne sont pas sans présenter d?inquiétantes zones d?ombre. Par ce livre, Staffan Westerlund a inauguré, en 1983, une série de romans policiers poussant plus loin encore que Sjöwall/Wahlöö l?analyse à la loupe d?une société malade de l?argent et de crimes échappant souvent à la compétence d?une police d?ailleurs bien débordée.

| SKU: | 9782070314171 |
| wmi_id_distributeur: | Not set |
| Is Salable (from plugin): | Yes (In Stock) |
| Is Salable (direct MSI check): | Yes (In Stock) |
| Distributor Name: | Par défaut |
| Availability Value: | 0 |
| Availability Label: | Epuisé |
| Match Result: | |
| Default Availability (Config): | 0 - Epuisé |
| Raw Config Mapping: |
Array
(
[_1772119784121_121] => Array
(
[id] => 12707000
[name] => 12707000
[availability] => 1
[activation_attribute] => 1
)
)
|
| EAN | 9782070314171 |
|---|---|
| Titre | L'Institut de recherches. Une enquête d'Inga-Lisa Ostergren |
| Auteur | Westerlund Staffan ; Bouquet Philippe |
| Editeur | FOLIO |
| Largeur | 109 |
| Poids | 184 |
| Date de parution | 20050120 |
| Nombre de pages | 343,00 € |
Pourquoi choisir Molière ?
Du même auteur
-

Murmures sous la neige
Westerlund Kate ; Oral Feridun ; Duteil JulieTrois petits lapins entendent un murmure sous la neige et en creusant, ils découvrent un ours en peluche en bien mauvais état. Avec l'aide de leur ami, le gros ours, ils vont lui redonner fière allure et, grâce à tous les oiseaux de la forêt, essayer de retrouver l'enfant qui a perdu son nounours. Le Jour de Noël, une surprise l'attendra devant sa porte.ÉPUISÉVOIR PRODUIT14,20 € -

La glace brisée
Westerlund Kate ; Tharlet Eve ; Duteil JulieAu coeur de l'hiver, alors que la neige recouvre le lac et les collines avoisinantes, tous ne pensent qu'à une chose: la grande course de vitesse en patin à glace. Chacun cherche bien sûr l'idée qui lui permettra de gagner. Le lapin est sûr d'être le plus rapide, l'écureuil fait confiance à ses calculs de trajectoire, la tortue garde espoir jusqu'à ce que la glace change le cours des choses. Mais doit-on vraiment arriver le premier pour gagner?ÉPUISÉVOIR PRODUIT14,20 € -

Monsieur Marius
Westerlund Kate ; Tharlet Eve ; Duteil JulieChaque année, dès que tombent les premiers flocons, Chloé et Léa ont l'habitude de faire un grand bonhomme de neige qu'elles appellent Monsieur Marius. Tous les hivers, il leur rend ainsi visite dans leur jardin. Cette année cependant, Léa fait en plus un petit chat de neige pour tenir compagnie à Monsieur Marius, tout blanc, tacheté de noir. Lorsqu'elle aperçoit ce joli chat, une nouvelle voisine, Manon, n'a plus qu'un souhait: avoir un chaton tout pareil comme cadeau de Noël. En ce soir de fête, les souhaits, dit-on, se réalisent parfois...ÉPUISÉVOIR PRODUIT14,20 € -

Le secret des oiseaux
Westerlund Kate ; Oral Feridun ; Duteil JulieRésumé : Lorsque le vieil hibou raconte aux oiseaux, comme chaque année, l'histoire de Noël, ceux-ci lui demandent pourquoi les humains ne transmettent plus comme autrefois le message de Noël. Les oiseaux décident alors de rappeler ce beau message de paix au monde par l'intermédiaire des enfants. Dans la deuxième histoire, trois lapins et deux souris trouvent sous la neige un ours en peluche. Il a l'air triste et en si mauvais état. Ils ne peuvent pas le laisser ainsi dehors, dans le froid. Aussi, ils l'emportent chez leur ami, le vieil ours. Il saura quoi faire. Deux histoires en un livre où la beauté des paysages de neige le dispute à la sensibilité de ces récits qui ressuscitent la magie de Noël pour les enfants.ÉPUISÉVOIR PRODUIT17,00 €
Du même éditeur
-
La Dame à la Licorne
Chevalier TracyDésireux d'orner les murs de sa nouvelle demeure parisienne, le noble Jean Le Viste commande une série de six tapisseries à Nicolas des Innocents, miniaturiste renommé à la cour du roi de France, Charles VIII. Surpris d'avoir été choisi pour un travail si éloigné de sa spécialité, l'artiste accepte néanmoins après avoir entrevu la fille de Jean Le Viste dont il s'éprend. La passion entraînera Nicolas dans le labyrinthe de relations délicates entre maris et femmes, parents et enfants, amants et servantes. En élucidant le mystère d'un chef-d'oeuvre magique, Tracy Chevalier ressuscite un univers de passion et de désirs dans une France où le Moyen Age s'apprête à épouser la Renaissance. Tracy Chevalier est américaine et vit à Londres depuis 1984 avec son mari et son fils. Son roman La jeune fille à la perle a rencontré un succès international.EN STOCKCOMMANDER9,50 € -
Les premiers temps de l'Eglise. De saint Paul à saint Augustin
COLLECTIFL'histoire du christianisme commence par l'acte de foi des disciples juifs de Jésus devant son tombeau vide: ils croient en sa résurrection et le reconnaissent comme le Messie annoncé dans la Bible. Le christianisme n'est alors qu'une de ces nombreuses religions de salut, qui multiplient les adeptes dans le monde gréco-romain. Mais d'emblée, il définit le salut comme un événement historique unique et non comme le résultat d'initiations individuelles à la façon des religions à mystères; il donne à cet événement uneportée universelle, et ouvre la communauté de Jérusalem au monde polyglotte et diversifié que vient d'unifier l'empire romain. Par là, il lie son destin à celui de Rome, ce qu'affirment très tôt les auteurs chrétiens: l'Église et l'Empire sont les deux seules structures de l'Antiquité à penser la mondialisation, ce qui facilitera la christianisation de l'État et du pouvoir au IVe siècle, après celle de la société. Or, quoi qu'on en ait, il est impossible de restituer une histoire linéaire et complète de l'Église primitive, de Jésus à saint Augustin, non plus qu'une histoire complète de la christianisation de l'Empire. La nature des sources - le plus souvent indirectes, apologétiques ou postérieures aux événements - ne permet que des approches ponctuelles, diversifiées, particulièrementriches pour certaines régions comme la Palestine, Rome et, plus encore, l'Asie Mineure. C'est donc une histoire partielle, en kaléidoscope, à travers une Bible plurielle et des groupes éclatés, très personnalisés, que retracent une soixantaine d'historiens, archéologues et biblistes, tous spécialistes de ces cinq siècles décisifs. Les chapitres de cet ouvrage, remis à jour et complétés pour ce volume, ont initialement paru dans la revue Le monde de la Bible. Il est le troisième et dernier volume du triptyque commencé, dans cette même collection, avec Le monde de la Bible (n° 88) et Aux origines du christianisme (n° 98).ÉPUISÉVOIR PRODUIT16,30 € -
A mon fils à l'aube du troisième millénaire
Sinoué GilbertCe n'est pas un voyage de plaisance qui t'attend. Oh non! Nous n'irons pas à Disneyland ni au parc Astérix. Je t'emmène ailleurs. Là où la majorité des grandes personnes refuse de se rendre parce qu'elles n'ont plus le temps ou se sont tellement accoutumées à côtoyer la déraison que la sagesse leur semble définitivement hors de portée. Ce n'est pas un projet prémédité. Je l'avoue, je n'ai rien étudié du parcours. Nous improviserons.Mais il faut que tu voies.Je te livre tout en vrac. Ce sera à toi, à vous, de faire le tri et de décider s'il faut laisser le monde se déconstruire ou tenter de réparer les dégâts. Et si d'en bâtir un tout neuf vous semble l'utopie suprême, alors surtout n'hésitez pas. Rien n'est plus jubilatoire que de transformer une utopie en réalité. "ÉPUISÉVOIR PRODUIT4,10 € -
L'Univers chiffonné. Edition revue et augmentée
Luminet Jean-PierreQuelle est la forme de l'Univers? Est-il courbe, refermé sur lui-même? Est-il en expansion? Vers quoi tend-il? L'espace serait-il "chiffonné" au point de créer des images fantômes des lointaines galaxies? Spécialiste des trous noirs et du big-bang, Jean-Pierre Luminet nous fait voyager dans de surprenants couloirs de l'espace-temps où topologies de l'Univers, explorations de l'infini et mirages cosmiques conjuguent leurs mystérieux attraits pour dérouter nos sens. La construction de l'ouvrage épouse la forme de son sujet une lecture à multiples entrées, des pistes à explorer pour s'y perdre, bifurquer à nouveau ou revenir en arrière, au gré du plaisir ou de la curiosité de chacun. Anecdotes cocasses et révélations historiques étonnantes agrémentent ce parcours à la recherche des secrets de la beauté sidérale.ÉPUISÉVOIR PRODUIT12,60 €
De la même catégorie
-
La lionne blanche
Mankell Henning ; Gibson AnnaAvril 1992. En Scanie, Louise Åkerblom, jeune mère de famille et agente immobilière vient de conclure une affaire. Il fait beau. C'est vendredi. Elle a acheté des gâteaux pour le dîner familial. Elle prend sa voiture pour visiter une dernière maison et se retrouve sur un chemin qu'elle n'aurait jamais dû emprunter : un homme l'abat froidement d'une balle en plein front. Peu auparavant, en Afrique du Sud, dans la province du Transkei, le tueur professionnel Victor Mabasha, qui croupit dans un bidonville, se voit confier une mission inespérée. Ses commanditaires sont des Blancs, comme d'habitude. Mais cette fois, des Afrikaners haut placés, opérant au coeur des services secrets sud-africains. Sa cible, un homme politique de premier plan. Le Président Frederik De Klerk ? Il n'en sait pas plus. Quelques jours plus tard, le corps de Louise est retrouvé au fond d'un puits, à Skurup, aux environs d'Ystad, par Wallander et son équipe qui enquêtaient déjà sur sa disparition. Mais le passé de la victime est désespérément sans histoire. Pas le moindre indice. Quelques jours plus tard, une maison explose à Skurup. Des débris de radio sophistiquée, de revolver et le doigt sectionné d'un homme noir sont retrouvés dans les décombres. Après avoir tourné en rond, l'enquête démarre véritablement. Y-a-t-il un lien entre l'explosion et le meurtre ? La suite est hautement imprévisible : un téléscopage vertigineux entre la banale réalité quotidienne de la Scanie et la lutte sans merci qui oppose, au même moment, à l'autre bout du monde, les partisans forcenés de la suprématie blanche et les artisans tout aussi déterminés - De Klerk et Mandela - de l'abolition de l'apartheid et du processus de démocratisation. Mais que sait Wallander de l'apartheid ? Que sait-il d'une façon générale de la situation internationale ? Par exemple, sait-il qu'il peut exister une relation entre l'ex-KGB et les Afrikaners fascistes ? Il y a tout juste dix ans, le 27 avril 2004, au terme de premières élections libres, l'Afrique du Sud se choisissait Nelson Mandela comme Président. Le point de départ ici pour Henning Mankell est pourtant une tentative d'assassinat contre Mandela, peu après sa libération, par des Afrikaners extrémistes. Chargé d'enquêter sur la disparition d'une mère de famille exécutée par un ex-agent du KGB, lequel entraînait en Suède le tueur noir à la solde des fascistes blancs, Wallander est habilement introduit par son créateur dans le climat politique confus de l'Afrique du Sud, au moment où le Président De Klerk s'efforce d'abolir l'apartheid et de faire de son pays la "nation arc-en ciel."ÉPUISÉVOIR PRODUIT9,90 € -
Recherchée
Alvtegen Karin ; Bouquet PhilippeDepuis plusieurs années, Sibylla vit dans l'ombre, fuyant le souvenir de son enfance, en marge de la société dans laquelle elle ne se reconnaît pas. Mais elle est soudain projetée sur le devant de la scène et fait la " une " des journaux : un homme a été sauvagement assassiné, un homme avec qui elle a justement passé la soirée. Tout le pays la recherche... Bientôt de nouveaux meurtres surviennent tous signés d'un prénom : le sien... Traquée, seule, Sibylla n'a pour seul allié qu'un adolescent, Patrik, à qui elle confie les secrets de son passé. Ensemble, ils mènent l'enquête pour retrouver le véritable assassin.ÉPUISÉVOIR PRODUIT7,10 € -
Arsène Lupin : L'aiguille creuse
Leblanc MauriceRésumé : Un ouvrage à étudier en classe, idéal pour les élèves de 4e-3e. Le domaine du comte de Gesvres est " visité " en pleine nuit par des cambrioleurs. La fille du comte, et sa nièce, surprennent un homme en train de s'enfuir à travers le parc en transportant ce qui semble être un objet encombrant. Le secrétaire de ce dernier, est retrouvé mort. Seules l'arme du crime et une casquette de chauffeur ont été retrouvées... Un texte intégral accompagné de notes, d'aides à la compréhension de l'oeuvre et de clés d'analyse.ÉPUISÉVOIR PRODUIT4,45 € -
Félicie est là
Simenon GeorgesFélicie est partie faire les courses. À son retour, Jules Lapie, le paisible retraité dont elle tient le ménage, a été assassiné. Le commissaire Maigret, avec sa sagacité habituelle, a tout de suite compris que la jeune fille au physique ingrat savait quelque chose, que derrière ses airs revêches elle cachait un coeur tendre... Comment l'amener à se confier? Qui protège-t-elle en gardant le silence? Rarement un témoin aura donné autant de fil à retordre au célèbre commissaire...ÉPUISÉVOIR PRODUIT6,60 €








